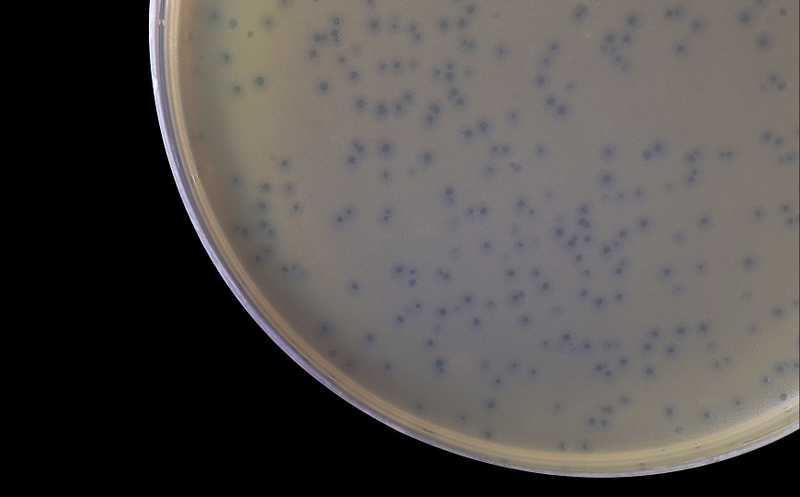

Бактерии вызывают у других бактерий чувствительность к фагам, чтобы получить преимущество
Бактерии используют особые вещества против конкурентов, причем не всегда они действуют напрямую, как антибиотики. Исследователи из США показали, что некоторые штаммы почвенной бактерии Streptomyces sp. вырабатывают сидерофор целихелин с высокой аффинностью к железу. При недостатке железа их конкурент Bacillus subtilis не может вовремя уйти в состояние покоя и защитить себя от распространения фага SPO1. Авторы также изучили молекулярные механизмы повышенной чувствительности B. subtilis к фагам в этих условиях.
Микроорганизмы постоянно конкурируют между собой за ресурсы, для чего они выработали ряд стратегий. Одна из самых распространенных — использование вторичных метаболитов, которые убивают другие микроорганизмы, мешают им прикрепляться к поверхностям или поглощать нутриенты. Исследователи из США предположили, что вторичные метаболиты могут сделать конкурентов более чувствительными к вирусным патогенам (фагам). Действительно, такой механизм обнаружили при конкуренции почвенных микроорганизмов Streptomyces sp. и Bacillus subtilis.
Актиномицеты изолировали из почвы и выращивали на агаре. Вокруг подросших колоний высаживали B. subtilis и фаг SPO1. Без колоний актиномицетов фаговые бляшки были маленькими (0,11 мм2), но в присутствии нескольких бактерий из 97 проверенных бляшки значительно увеличивались (до 1,96 мм2 возле колонии Streptomyces sp. I8-5). Эффект зависел от расстояния до колонии. Предположительно, бактерии вырабатывали вещества, способствующие росту бляшек, или поглощали вещества, ингибирующие рост. Однако стерильная среда, на которой выращивали I8-5, увеличивала размер бляшек в 30 раз, так что дело, скорее всего, в секретируемом компоненте или компонентах.
С помощью хроматографии и тандемной масс-спектрометрии авторы идентифицировали вторичный метаболит, делающий B. subtilis более чувствительным к фагам, — сидерофор целихелин с высокой аффинностью к железу. Кластер генов для биосинтеза целихелина был найден у Streptomyces sp. I8-5 при секвенировании.
Интересно, что другие распространенные сидерофоры (феррихром, энтеробактин и линейный энтеробактин) не влияли на размеры бляшек. Ранее было показано, что бактерия B. subtilis способна импортировать некоторые ксеносидерофоры, вырабатываемые другими микроорганизмами. Авторы предположили, что способствуют заражению только сидерофоры, которые B. subtilis не может импортировать, и что целихелин связывает железо и делает его недоступным для B. subtilis. Действительно, хелатор EDDHA, который обладает тем же эффектом, увеличивал размер фаговых бляшек. А добавление железа нивелировало эффект целихелина и EDDHA. Таким образом, недостаток железа каким-то образом делает B. subtilis более чувствительной к SPO1.
Авторы изучили этот механизм. Сначала они показали, что при дефиците железа фаги не реплицируются быстрее контрольных. Но бляшки образовывались дольше, проходили репродуктивный цикл больше раз и потому были больше.
Тогда ученые предположили, что недостаток железа влияет на бактерию-хозяина и ее вхождение в состояние покоя. Фаги лучше размножаются и формируют бляшки в метаболически активных клетках, но, если бактерия войдет в состояние покоя, это может подавить пролиферацию фага. Вход в покоящееся состояние можно считать механизмом резистентности.
Недостаток питательных веществ и другие стрессоры у B. subtilis активируют транскрипционный регулятор Spo0A, который отвечает за переход от экспоненциального вегетативного роста к стационарной фазе и споруляции. У мутантного штамма с постоянно активированным Spo0A образование фаговых бляшек подавлено. Но для перехода к стационарной фазе необходима достаточная концентрация железа внутри клетки. Целихелин и EDDHA подавляли активацию Spo0A, а добавление железа восстанавливало. Нокаут Spo0A «запирает» B. subtilis на стадии вегетативного роста. Такой мутант образует большие фаговые бляшки, которые не становятся больше при ограничении доступности железа.
Авторы предположили, что подавление споруляции (через подавление активации Spo0A) приводит к увеличению бляшек. Для проверки они изучили мутанты по генам, регулирующим споруляцию, — spoIIAA, sigF и spoIIE. Если подавление споруляции действительно приводит к увеличению бляшек, тот эти мутанты должны иметь тот же фенотип, что и мутант по Spo0A. Однако у мутантов по spoIIAA, sigF и spoIIE бляшки были такими же маленькими, как и у бактерий дикого типа, и увеличивались при недостатке железа.
Но до споруляции Spo0A активирует и другие пути, опосредуемые SinI/SinR и AbrB. Серия экспериментов показала, что ни один из них в одиночку не может объяснить ограничение роста бляшек. Возможно, они действуют совместно.
Поскольку целихелин, секретируемый Streptomyces sp. I8-5, способствует фаговой инфекции B. subtilis, авторы предположили, что этот сидерофор обеспечивает Streptomyces конкурентное преимущество перед B. subtilis в присутствии фагов. Это предположение подтвердилось, присутствие фагов и Streptomyces sp. I8-5 привело к тому, что соотношение бактерий Streptomyces и B. subtilis составило 15:1. Добавление железа убрало конкурентное преимущество Streptomyces.
Тот же эффект был показан для других фагов Bacillus (SP10, SP50 и Goe2) и для трех из пяти других штаммов (Am9, Am23, Am62, R1B3, I8-24). Таким образом, целихелин дает вырабатываемому его штамму конкурентное преимущество, делая другие бактерии более чувствительными к фагам.
Обнаружен общий механизм, позволяющий фагам сосуществовать на одних штаммах бактерий
Источник:
Zhiyu Zang, et al. Streptomyces secretes a siderophore that sensitizes competitor bacteria to phage infection // Nature Microbiology (2025), published 08 January 2025, DOI: 10.1038/s41564-024-01910-8


 Меню
Меню





 Все темы
Все темы




 0
0












